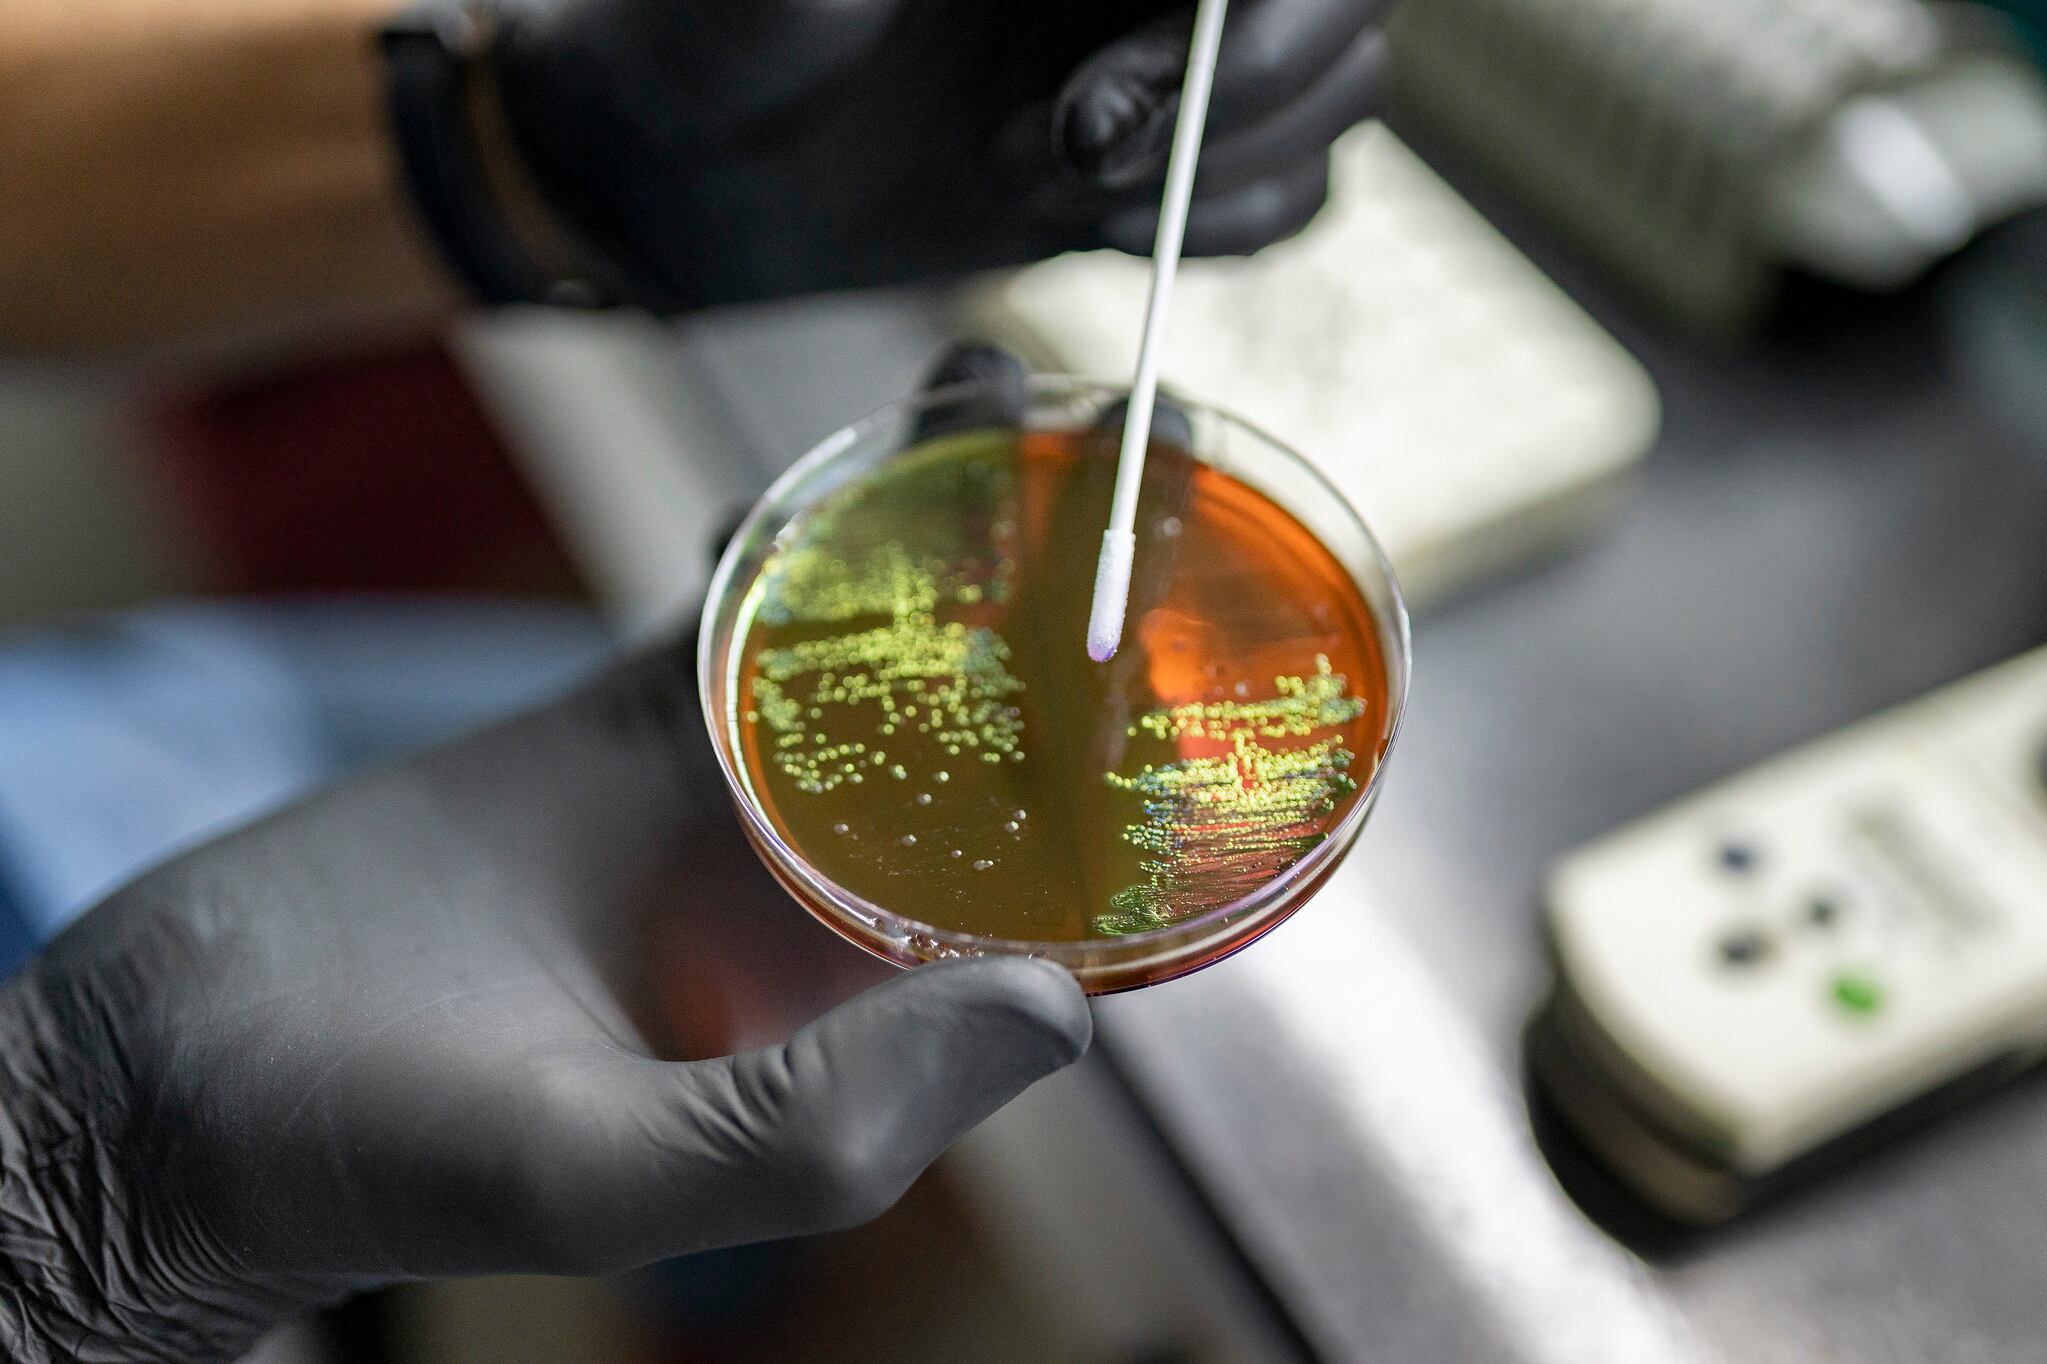

Cuarta Reunión de la Red de Centros Colaboradores de Vigilancia y Evaluación de la RAM
Argentina tiene uno de los mejores sistemas de vigilancia de la resistencia antimicrobiana
La líder del Programa Especial de Resistencia Antimicrobiana de la Organización Panamericana de Salud (OPS), Pilar Ramón-Pardo, aseguró que “Argentina tiene uno de los mejores sistemas de vi